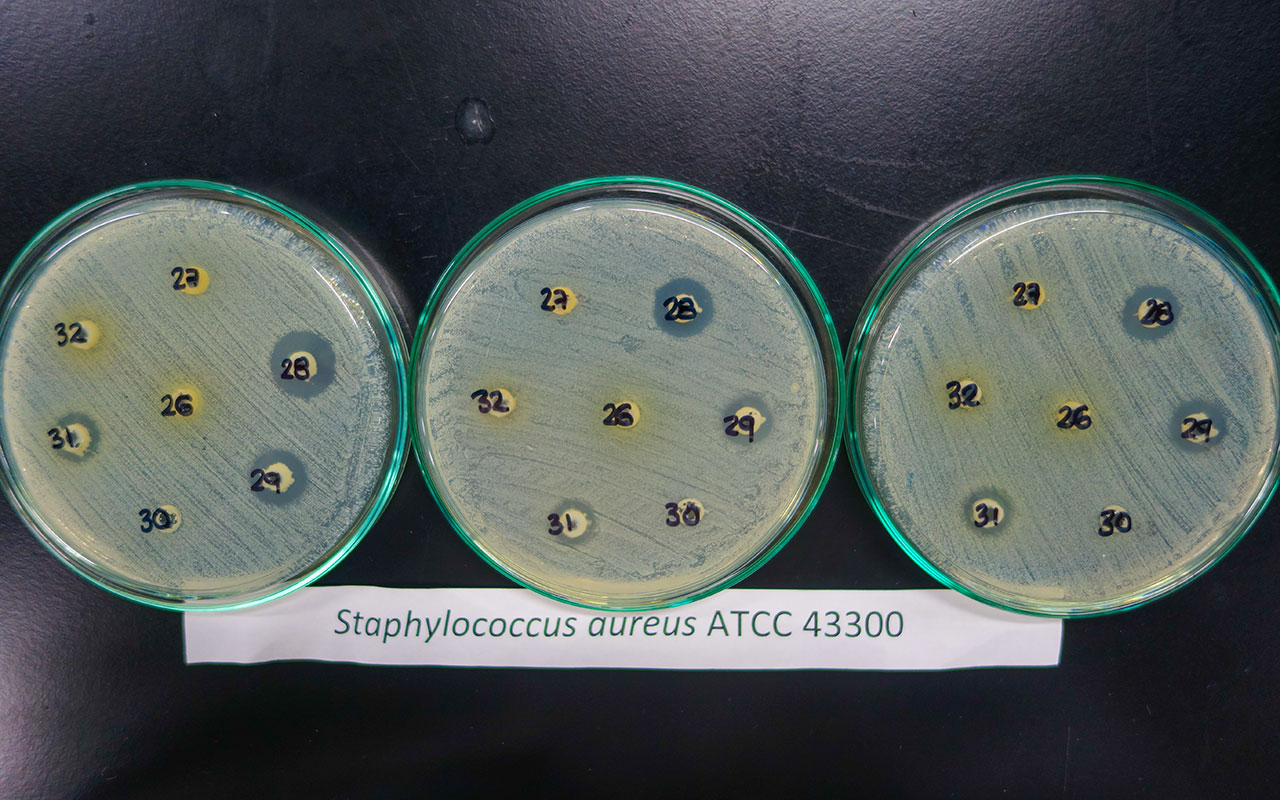
Programa VAR

Evaluation and Use of Marine and Coastal Resources Program
This program evaluates the status and assesses the biological, economic and social potential of marine and coastal natural resources for their conservation and sustainable use. Applying interdisciplinary analysis tools, the program generates basic and applied research to propose sustainable use systems, develop clean production technologies and advise decision-making and policy formulation for the sustainable economic development of biodiversity.
Research Lines and Laboratories
Economic Valuation - VAE
This line focuses on conducting research in the environmental economics and natural resources framework to evidence the importance of marine and coastal biodiversity and ecosystem services in the decision-making process face to alternative uses and optimal allocation of natural resources. Research areas include integrated valuation of biodiversity and ecosystem services, the livelihood characterization of marine coastal communities and the proposition of economic mechanisms in the management.
Use and Sustainable Production - UPS
This line assesses the status and potential of the main marine and coastal resources with emphasis on fishery resources, in order to propose strategies for sustainable use under an ecosystem and participatory approach. Areas of research include fisheries ecology, fish stock assessment, fisheries modeling and management.
Marine Bioprospecting – BIM
This line identifies active principles of marine organisms with potential application in health, industry and environmental (bioremediation), through the chemical and biological characterization of their genes. The research activities are articulated as follows: obtaining and characterizing extracts, fractions and molecules obtained from marine organisms; assessing the potential use of substances obtained through bioguided test; the cultivation and evaluation of the potential of microalgae and marine micro-organisms; and the development of antimicrobial trials in marine living organisms and cell cultures.
Marine bioprospecting lab (LabBIM)
The LabBIM is designed to obtain extracts and fractions of marine organisms, as well as the separation and basic chemical characterization of the molecules or mixtures obtained in order to evaluate their potential through the development of biological activity testing. In addition, can be performed tests of ecology and chemical ecology working with various organisms, maintenance and feeding systems, cell cultures and microalgae. The installed capacity also supports the development of fishery ecology projects, mainly of histological slides and the analysis of gonadal material and other tissues used on studies of trophic ecology, reproduction and population dynamics.
Close
Diganos su opinión
A través de éstas encuestas se busca medir el grado de satisfacción de nuestros usuarios frente a los servicios brindados por el INVEMAR.
Encuesta de percepción de la gestión institucional
Evaluación de los servicios prestados en el CDO
Encuesta de satisfaccion para los servicios del museo de Historia Natural Marina de Colombia